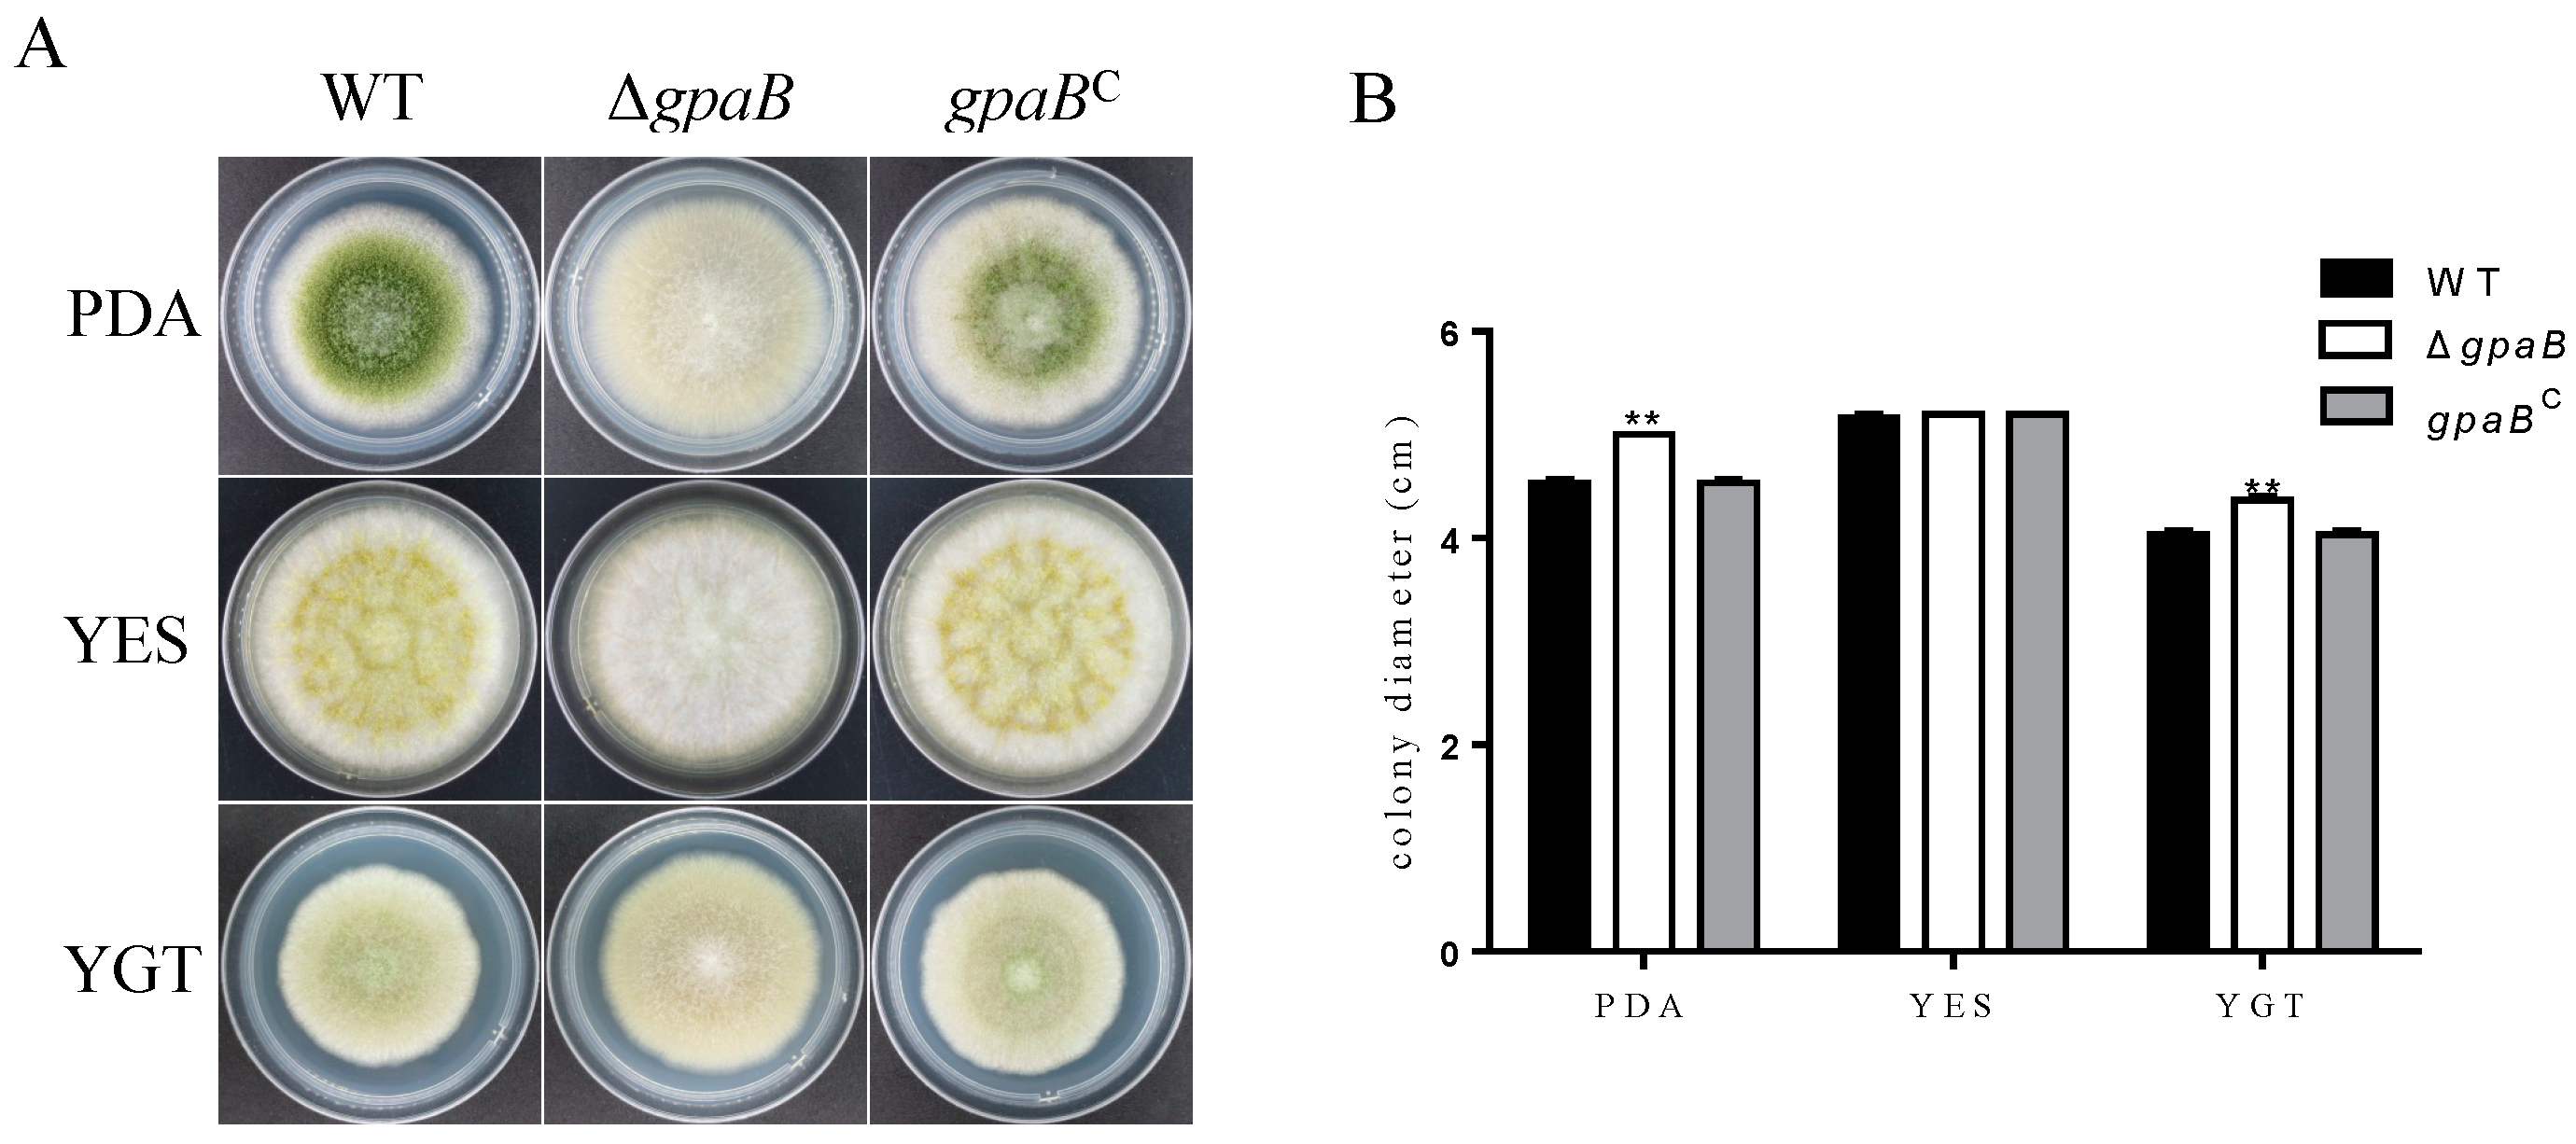
Toxins 10 00117 g003 Toxins 10 00117 g003

G Protein α Subunit GpaB is Required for Asexual Development, Aflatoxin Biosynthesis and Pathogenicity by Regulating cAMP Signaling in Aspergillus flavus
Abstract
1. Introduction
2. Results
2.1. Identification of G Protein α Subunits in Aspergillus flavus
2.2. Generation of Target Strains
2.3. gpaB Is Involved in Pigmentation and Colonial Morphology in A. flavus
2.4. gpaB Is Required for Conidiation and Negatively Regulates Sclerotia Formation in A. flavus
2.5. gpaB Is Involved in Stress Responses in A. flavus
2.6. gpaB Regulates AF Biosynthesis in A. flavus
2.7. gpaB Is Essential for A. flavus Pathogenicity on Maize Kernels
2.8. gpaB Regulates cAMP/PKA Signaling in A. flavus
3. Discussion
4. Conclusions
5. Materials and Methods
5.1. Strains and Culture Conditions
5.2. Strain Construction
5.3. Phylogenetic Analysis
5.4. AF Analysis
5.5. Fungal Virulence Assays on Corn
5.6. Real-Time Quantitative Reverse Transcription PCR
5.7. Intracellular cAMP and PKA Activities Measurement
5.8. Statistical Analysis
Acknowledgments
Author Contributions
Conflicts of Interest
References
- Chalivendra, S.C.; DeRobertis, C.; Chang, P.K.; Damann, K.E. Cyclopiazonic acid is a pathogenicity factor for Aspergillus flavus and a promising target for screening germplasm for ear rot resistance. MPMI 2017, 30, 361–373. [Google Scholar] [CrossRef] [PubMed]
- Amaike, S.; Keller, N.P. Aspergillus flavus. Ann. Rev. Phytopathol. 2011, 49, 107–133. [Google Scholar] [CrossRef] [PubMed]
- Oliver, B.G.; Panepinto, J.C.; Askew, D.S.; Rhodes, J.C. cAMP alteration of growth rate of Aspergillus fumigatus and Aspergillus niger is carbon-source dependent. Microbiology 2002, 148, 2627–2633. [Google Scholar] [CrossRef] [PubMed][Green Version]
- Xue, C.; Hsueh, Y.P.; Chen, L.; Heitman, J. The RGS protein Crg2 regulates both pheromone and cAMP signalling in Cryptococcus neoformans. Mol. Microbiol. 2008, 70, 379–395. [Google Scholar] [CrossRef] [PubMed]
- Gronover, C.S.; Kasulke, D.; Tudzynski, P.; Tudzynski, B. The role of G protein alpha subunits in the infection process of the gray mold fungus Botrytis cinerea. MPMI 2001, 14, 1293–1302. [Google Scholar] [CrossRef] [PubMed]
- Li, L.; Wright, S.J.; Krystofova, S.; Park, G.; Borkovich, K.A. Heterotrimeric G protein signaling in filamentous fungi. Ann. Rev. Microbiol. 2007, 61, 423–452. [Google Scholar] [CrossRef] [PubMed]
- Reithner, B.; Brunner, K.; Schuhmacher, R.; Peissl, I.; Seidl, V.; Krska, R.; Zeilinger, S. The G protein alpha subunit Tga1 of Trichoderma atroviride is involved in chitinase formation and differential production of antifungal metabolites. Fungal Genet. Biol. 2005, 42, 749–760. [Google Scholar] [CrossRef] [PubMed]
- Jain, S.; Akiyama, K.; Mae, K.; Ohguchi, T.; Takata, R. Targeted disruption of a G protein alpha subunit gene results in reduced pathogenicity in Fusarium oxysporum. Curr. Genet. 2002, 41, 407–413. [Google Scholar] [CrossRef] [PubMed]
- Hicks, J.K.; Yu, J.H.; Keller, N.P.; Adams, T.H. Aspergillus sporulation and mycotoxin production both require inactivation of the FadA G alpha protein-dependent signaling pathway. EMBO J. 1997, 16, 4916–4923. [Google Scholar] [CrossRef] [PubMed]
- Song, N.; Dai, Q.; Zhu, B.; Wu, Y.; Xu, M.; Voegele, R.T.; Gao, X.; Kang, Z.; Huang, L. Galpha proteins Gvm2 and Gvm3 regulate vegetative growth, asexual development, and pathogenicityon apple in Valsa mali. PLoS ONE 2017, 12, e0173141. [Google Scholar]
- Liu, S.; Dean, R.A. G protein alpha subunit genes control growth, development, and pathogenicity of Magnaporthe grisea. MPMI 1997, 10, 1075–1086. [Google Scholar] [CrossRef] [PubMed]
- Chang, M.H.; Chae, K.S.; Han, D.M.; Jahng, K.Y. The GanB Galpha-protein negatively regulates asexual sporulation and plays a positive role in conidial germination in Aspergillus nidulans. Genetics 2004, 167, 1305–1315. [Google Scholar] [CrossRef] [PubMed]
- Bolker, M. Sex and crime: Heterotrimeric G proteins in fungal mating and pathogenesis. Fungal Genet. Biol. 1998, 25, 143–156. [Google Scholar] [CrossRef] [PubMed]
- Lafon, A.; Seo, J.A.; Han, K.H.; Yu, J.H.; d’Enfert, C. The heterotrimeric G-protein GanB(α)-SfaD(β)-GpgA(γ) is a carbon source sensor involved in early camp-dependent germination in Aspergillus nidulans. Genetics 2005, 171, 71–80. [Google Scholar] [CrossRef] [PubMed]
- Kays, A.M.; Rowley, P.S.; Baasiri, R.A.; Borkovich, K.A. Regulation of conidiation and adenylyl cyclase levels by the galpha protein GNA-3 in Neurospora crassa. Mol. Cell. Biol. 2000, 20, 7693–7705. [Google Scholar] [CrossRef] [PubMed]
- Kubler, E.; Mosch, H.U.; Rupp, S.; Lisanti, M.P. Gpa2p, a G-protein alpha-subunit, regulates growth and pseudohyphal development in Saccharomyces cerevisiae via a camp-dependent mechanism. J. Biol. Chem. 1997, 272, 20321–20323. [Google Scholar] [CrossRef] [PubMed]
- Shin, K.S.; Yu, J.H. Expression and activity of catalases is differentially affected by GpaA (Ga) and FlbA (regulator of G protein signaling) in Aspergillus fumigatus. Mycobiology 2013, 41, 145–148. [Google Scholar] [CrossRef] [PubMed][Green Version]
- Emri, T.; Szilagyi, M.; Justyak, A.; Pocsi, I. Heterotrimeric G protein mediated regulation of proteinase production in Aspergillus nidulans. Acta Microbiol. Immunol. Hung. 2008, 55, 111–117. [Google Scholar] [CrossRef] [PubMed]
- Liebmann, B.; Gattung, S.; Jahn, B.; Brakhage, A.A. cAMP signaling in Aspergillus fumigatus is involved in the regulation of the virulence gene pksP and in defense against killing by macrophages. Mol. Genet. Genom. 2003, 269, 420–435. [Google Scholar] [CrossRef] [PubMed]
- Liebmann, B.; Muller, M.; Braun, A.; Brakhage, A.A. The cyclic AMP-dependent protein kinase a network regulates development and virulence in Aspergillus fumigatus. Infect. Immun. 2004, 72, 5193–5203. [Google Scholar] [CrossRef] [PubMed]
- Krystofova, S.; Borkovich, K.A. The heterotrimeric G-protein subunits GNG-1 and GNB-1 form a Gbetagamma dimer required for normal female fertility, asexual development, and galpha protein levels in Neurospora crassa. Eukaryot. Cell 2005, 4, 365–378. [Google Scholar] [CrossRef] [PubMed]
- Studt, L.; Humpf, H.U.; Tudzynski, B. Signaling governed by G proteins and cAMP is crucial for growth, secondary metabolism and sexual development in Fusarium fujikuroi. PLoS ONE 2013, 8, e58185. [Google Scholar] [CrossRef] [PubMed]
- Yang, K.; Qin, Q.; Liu, Y.; Zhang, L.; Liang, L.; Lan, H.; Chen, C.; You, Y.; Zhang, F.; Wang, S. Adenylate cyclase AcyA regulates development, aflatoxin biosynthesis and fungal virulence in Aspergillus flavus. Front. Cell. Infect. Microbiol. 2016, 6, 190. [Google Scholar] [CrossRef] [PubMed]
- Yang, K.; Liu, Y.; Liang, L.; Li, Z.; Qin, Q.; Nie, X.; Wang, S. The high-affinity phosphodiesterase pdeH regulates development and aflatoxin biosynthesis in Aspergillus flavus. Fungal Genet. Biol. 2017, 101, 7–19. [Google Scholar] [CrossRef] [PubMed]
- Liu, J.; Ding, P.; Sun, T.; Nitta, Y.; Dong, O.; Huang, X.; Yang, W.; Li, X.; Botella, J.R.; Zhang, Y. Heterotrimeric G proteins serve as a converging point in plant defense signaling activated by multiple receptor-like kinases. Plant Physiol. 2013, 161, 2146–2158. [Google Scholar] [CrossRef] [PubMed]
- Lafon, A.; Han, K.H.; Seo, J.A.; Yu, J.H.; d’Enfert, C. G-protein and cAMP-mediated signaling in aspergilli: A genomic perspective. Fungal Genet. Biol. 2006, 43, 490–502. [Google Scholar] [CrossRef] [PubMed]
- Regenfelder, E.; Spellig, T.; Hartmann, A.; Lauenstein, S.; Bolker, M.; Kahmann, R. G proteins in Ustilago maydis: Transmission of multiple signals? EMBO J. 1997, 16, 1934–1942. [Google Scholar] [CrossRef] [PubMed]
- Li, L.; Shen, G.; Zhang, Z.G.; Wang, Y.L.; Thompson, J.K.; Wang, P. Canonical heterotrimeric G proteins regulating mating and virulence of Cryptococcus neoformans. Mol. Biol. Cell 2007, 18, 4201–4209. [Google Scholar] [CrossRef] [PubMed]
- Alspaugh, J.A.; Pukkila-Worley, R.; Harashima, T.; Cavallo, L.M.; Funnell, D.; Cox, G.M.; Perfect, J.R.; Kronstad, J.W.; Heitman, J. Adenylyl cyclase functions downstream of the galpha protein Gpa1 and controls mating and pathogenicity of Cryptococcus neoformans. Eukaryot. Cell 2002, 1, 75–84. [Google Scholar] [CrossRef] [PubMed]
- Roze, L.V.; Beaudry, R.M.; Keller, N.P.; Linz, J.E. Regulation of aflatoxin synthesis by FadA/cAMP/protein kinase a signaling in Aspergillus parasiticus. Mycopathologia 2004, 158, 219–232. [Google Scholar] [CrossRef] [PubMed]
- Shimizu, K.; Keller, N.P. Genetic involvement of a camp-dependent protein kinase in a G protein signaling pathway regulating morphological and chemical transitions in Aspergillus nidulans. Genetics 2001, 157, 591–600. [Google Scholar] [PubMed]
- Chang, P.K.; Scharfenstein, L.L.; Mack, B.; Ehrlich, K.C. Deletion of the Aspergillus flavus orthologue of A. nidulans FluG reduces conidiation and promotes production of sclerotia but does not abolish aflatoxin biosynthesis. Appl. Environ. Microbiol. 2012, 78, 7557–7563. [Google Scholar]
- Chang, P.K.; Scharfenstein, L.L.; Wei, Q.; Bhatnagar, D. Development and refinement of a high-efficiency gene-targeting system for Aspergillus flavus. J. Microbiol. Methods 2010, 81, 240–246. [Google Scholar] [CrossRef] [PubMed]
- Lim, F.Y.; Sanchez, J.F.; Wang, C.C.; Keller, N.P. Toward awakening cryptic secondary metabolite gene clusters in filamentous fungi. Methods Enzymol. 2012, 517, 303–324. [Google Scholar] [PubMed]
- Yang, K.; Liang, L.; Ran, F.; Liu, Y.; Li, Z.; Lan, H.; Gao, P.; Zhuang, Z.; Zhang, F.; Nie, X.; et al. The DmtA methyltransferase contributes to Aspergillus flavus conidiation, sclerotial production, aflatoxin biosynthesis and virulence. Sci. Rep. 2016, 6, 23259. [Google Scholar] [CrossRef] [PubMed]
- Kale, S.P.; Milde, L.; Trapp, M.K.; Frisvad, J.C.; Keller, N.P.; Bok, J.W. Requirement of LaeA for secondary metabolism and sclerotial production in Aspergillus flavus. Fungal Genet. Biol. 2008, 45, 1422–1429. [Google Scholar] [CrossRef] [PubMed]
- Tsitsigiannis, D.I.; Keller, N.P. Oxylipins act as determinants of natural product biosynthesis and seed colonization in Aspergillus nidulans. Mol. Microbiol. 2006, 59, 882–892. [Google Scholar] [CrossRef] [PubMed]
- Liu, H.; Suresh, A.; Willard, F.S.; Siderovski, D.P.; Lu, S.; Naqvi, N.I. Rgs1 regulates multiple galpha subunits in Magnaporthe pathogenesis, asexual growth and thigmotropism. EMBO J. 2007, 26, 690–700. [Google Scholar] [CrossRef] [PubMed]
- Yang, Z.; Dickman, M. Regulation of cAMP and cAMP dependent protein kinase during conidial germination and appressorium formation in Colletotrichum trifolii. Physiol. Mol. Plant Pathol. 1997, 50, 117–127. [Google Scholar] [CrossRef]

| Gene ID | Name | Relative Expression Level | |
|---|---|---|---|
| WT | ΔgpaB | ||
| AFLA_029620 | abaA | 1.00 ± 0.02 | 0.17 ± 0.01 ** |
| AFLA_082850 | brlA | 1.00 ± 0.05 | 0.09 ± 0.01 ** |
| AFLA_131330 | nsdC | 1.21 ± 0.13 | 4.28 ± 0.21 *** |
| AFLA_020210 | nsdD | 0.86 ± 0.05 | 2.91 ± 0.11 ** |
| AFLA_040260 | sclR | 1.18 ± 0.18 | 7.20 ± 0.87 *** |
| AFLA_139360 | aflR | 0.88 ± 0.04 | 0.36 ± 0.03 *** |
| AFLA_139340 | aflS | 0.91 ± 0.09 | 0.26 ± 0.03 *** |
| AFLA_139210 | aflP | 1.11 ± 0.17 | 0.04 ± 0.0003 *** |
| Strain | Genotype Description | Reference |
|---|---|---|
| A. flavus CA14 PTs | Δku70, ΔpyrG | [33] |
| wildtype | Δku70, ΔpyrG::AfpyrG | This study |
| ΔgpaB | Δku70, ΔgpaB::AfpyrG | This study |
| ΔganA | Δku70, ΔgpaB::AfpyrG | This study |
| gpaBC | Δku70, ΔgpaB:: AfpyrG, gpaB(p):: gpaB::gfp::ptrA | This study |
| Primers | Sequence (5′-3′) | Application |
|---|---|---|
| AfpyrG/F | GCCTCAAACAATGCTCTTCACCC | AfpyrG |
| AfpyrG/R | GTCTGAGAGGAGGCACTGATGC | |
| P801/R | CAGGAGTTCTCGGGTTGTCG | |
| gpaB/P1 | ACGAGTAACACCCTGTGAATGG | gpaB deletion flanking regions |
| gpaB/P3 | GGGTGAAGAGCATTGTTTGAGGCGAACGGCATCAACCTATCACG | |
| gpaB/P4 | GCATCAGTGCCTCCTCTCAGACTGAGACTTTGTGGCATGGAGT | |
| gpaB/P6 | GTCCAGACCCTTCCTACAACTC | |
| gpaB/P2 | TTACCGTCACAACCCTTCAGC | gpaB deletion construct nest primers |
| gpaB/P5 | GTCCAGACCCTTCCTACAACTC | |
| gpaB/OF | GCCTATCACCAGTTCTCCCTT | gpaB mutant screen |
| gpaB/OR | CACATCATTGCCGCCAGAG | |
| ganA/P1 | CGTACTCGTTCCCTACTGACAG | ganA deletion flanking regions |
| ganA/P3 | GGGTGAAGAGCATTGTTTGAGGCAGTCCAATGGCAGCAGGTG | |
| ganA/P4 | GCATCAGTGCCTCCTCTCAGACCCTTTCTACGACACTTTGGC | |
| ganA/P6 | AAGGTGTTGGGTGGAGGGA | |
| ganA/P2 | TCGTTGTCGCTTACCTACTGC | ganA deletion construct nest primers |
| ganA/P5 | CTCCTTCCGCATTAGACACC | |
| ganA/OF | CAAGTTTATCTCGGCAATGTG | ganA mutant screen |
| ganA/OR | CTCCACTAAGCACTGGTCGT | |
| gpaB/R | GGCTCCAGCGCCTGCACCAGCTCCCAAGATACCTGAATCCTTCAAAG | gpaB mutant complement |
| AfpyrG-cm/F | GGATCCCGTAATCAATTGCCCATTGCCTCAAACAATGCTCTTCACCC | |
| ptrA/F | AATGGGGTGACGATGAGCC | ptrA |
| ptrA/R | AATGGGCAATTGATTACGGG | |
| gfp/F | GGAGCTGGTGCAGGCGCTGGAGCCGGTGCCATGGTGAGCAAGGGCGAGGA | GFP |
| gfp/R | TCAAAGATCTACCATGTACAGC | |
| trpC/F | TTGATGATTTCAGTAACGTTAATTAACGTTACTGAAATCATCAA | trpC terminator |
| trpC/R | AAGAGCGGCTCATCGTCACCCCATTAAGAAGGATTACCTCTAAACAA |
| Primers | Sequence (5′-3′) | Length | Application |
|---|---|---|---|
| actin-F | ACGGTGTCGTCACAAACTGG | 129 bp | RT-PCR for actin |
| actin-R | CGGTTGGACTTAGGGTTGATAG | ||
| abaA-F | TCTTCGGTTGATGGATGATTTC | 84 bp | RT-PCR for abaA |
| abaA-R | CCGTTGGGAGGCTGGGT | ||
| brlA-F | GCCTCCAGCGTCAACCTTC | 158 bp | RT-PCR for brlA |
| brlA-R | TCTCTTCAAATGCTCTTGCCTC | ||
| nsdC-F | GCCAGACTTGCCAATCAC | 153 bp | RT-PCR for nsdC |
| nsdC-R | CATCCACCTTGCCCTTTA | ||
| nsdD-F | GGACTTGCGGGTCGTGCTA | 167 bp | RT-PCR for nsdD |
| nsdD-R | AGAACGCTGGGTCTGGTGC | ||
| sclR-F | CAATGAGCCTATGGGAGTGG | 102 bp | RT-PCR for sclR |
| sclR-R | ATCTTCGCCCGAGTGGTT | ||
| aflR-F | AAAGCACCCTGTCTTCCCTAAC | 233 bp | RT-PCR for aflR |
| aflR-R | GAAGAGGTGGGTCAGTGTTTGTAG | ||
| aflS-F | CGAGTCGCTCAGGCGCTCAA | 134 bp | RT-PCR for aflS |
| aflS-R | GCTCAGACTGACCGCCGCTC | ||
| aflP-F | GATTGGGATGTGGTCATGCGATT | 181 bp | RT-PCR for aflP |
| aflP-R | GCCTGGGTCCGAAGAATGC |
© 2018 by the authors. Licensee MDPI, Basel, Switzerland. This article is an open access article distributed under the terms and conditions of the Creative Commons Attribution (CC BY) license (http://creativecommons.org/licenses/by/4.0/).
Share and Cite
Liu, Y.; Yang, K.; Qin, Q.; Lin, G.; Hu, T.; Xu, Z.; Wang, S. G Protein α Subunit GpaB is Required for Asexual Development, Aflatoxin Biosynthesis and Pathogenicity by Regulating cAMP Signaling in Aspergillus flavus. Toxins 2018, 10, 117. https://doi.org/10.3390/toxins10030117
Liu Y, Yang K, Qin Q, Lin G, Hu T, Xu Z, Wang S. G Protein α Subunit GpaB is Required for Asexual Development, Aflatoxin Biosynthesis and Pathogenicity by Regulating cAMP Signaling in Aspergillus flavus. Toxins. 2018; 10(3):117. https://doi.org/10.3390/toxins10030117
Chicago/Turabian StyleLiu, Yinghang, Kunlong Yang, Qiuping Qin, Guinan Lin, Tianran Hu, Zhangling Xu, and Shihua Wang. 2018. "G Protein α Subunit GpaB is Required for Asexual Development, Aflatoxin Biosynthesis and Pathogenicity by Regulating cAMP Signaling in Aspergillus flavus" Toxins 10, no. 3: 117. https://doi.org/10.3390/toxins10030117
APA StyleLiu, Y., Yang, K., Qin, Q., Lin, G., Hu, T., Xu, Z., & Wang, S. (2018). G Protein α Subunit GpaB is Required for Asexual Development, Aflatoxin Biosynthesis and Pathogenicity by Regulating cAMP Signaling in Aspergillus flavus. Toxins, 10(3), 117. https://doi.org/10.3390/toxins10030117
